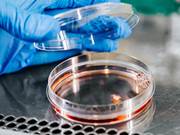

...commercialization of the Leda technology. LedaFlow® has been developed as a research project since 2002 and is based on a rigorous representation of the fundamental physical and chemical (compositional) properties of oil and gas flow, combined with experimental data from the SINTEF Multiphase Flow Laboratory at Tiller...
Søk i SINTEF
...going on for some time between the Norwegian Building Research Institute and SINTEF regarding a possible union of the Institute with SINTEF’s building and construction-related units. Both the Norwegian Building Research Institute and SINTEF are private foundations. Both of their boards of directors have...
February 15, Thorhild Widvey, Minister of Petroleum and Energy, will be visiting SINTEF and NTNU. In the course of a crowded four-hour programme the Minister will hear the latest news about the challenges and possibilities offered by hydrogen - and the very current topic of cleaning technology for gas-fired...

The project will document the technical and fishery-specific requirements for a new concept for coastal fishing vessels. For continued required investment in active and viable environments along the coastal line, it is important that the fleet group of small vessels is renewed, both in terms of vessel...

...of Fisheries and Coastal Affairs has initiated a study to look at the potential for increased added value in salmon and trout industry. The study will look at how value creation in the Norwegian aquaculture industry can be increased by increasing the value in the production of salmon and trout. The study...
...selected Centres of Excellence on CCS across Europe (Norway, Poland, France, Italy, Germany, Spain, Greece, UK, Netherlands and Switzerland). The mission is to develop (i.e. build and operate) a European distributed, goal-oriented, integrated Research Infrastructure. The goals are to: Provide a dynamic...

...media reports about absenteeism and Norwegian workers' morale. Very few of these stories have referred to research. We believe attitudes to work and absence are shaped before people enter the labor market. In this project we examined the attitudes towards absence and presence among more than 6 000 students...

...scientists Ole Edvard Kongstein, Ole S. Kjos, Ana M. Martinez and Edel Sheridan, all of SINTEF Materials and Chemistry Sunbeams and gusts of wind have one thing in common: they are unpredictable sources of energy that cannot be switched on and off according to our requirements. If we do not need the power...

Data collection has now started at two Norwegian rivers to find out how to improve both power generation and environmental conditions ReHydro – Demonstration of Sustainable Hydropower Refurbishment, aims to explore innovative solutions to raise the impact of hydropower as an energy source within the...
Visual storytelling Tiny brains, hearts and lungs can help cure disease Mini-organs help researchers study many illnesses for which there are currently no treatments. By Idun Haugan and Christina Benjaminsen – Published 28.11.2024 Many great discoveries and inventions stem from basic research, especially...

ENGAGE seeks to strengthen the cooperation between the population, emergency organizations and authorities to prevent, prepare for, respond to and recover from disasters. Improve the interaction between the actors in disaster management In order to achieve society's ability to cope with disasters (its...

Viewpoints Somewhat overshadowed by last year’s debate here in Norway about how we might match the massive green subsidies being offered in the US and EU, the prestigious American business magazine Forbes dug out a modern rags-to-riches story from Sunnmøre in mid-Norway. Under the headline ‘Five Green...
Establish a mathematical model representing the salmon biomass dynamics in a typical sea cage grow-out setting and investigate the feasibility of the concepts of state observers and optimal filtering (or model-based estimation) applied to the problem of biomass estimation....
...arranged additional metocean and ice workshops in Tromsø and Tronddheim. Met.no has prepared updated ice data for the Olga basin in the eastern Barents Sea. As an outcome of these meetings the project partners have proposed a follow-up activity to collect long term metocean and ice data for selected locations...

...knowledge on safety concerns associated with a widespread roll-out of H2 technology represents a major bottleneck for industry, authorities, end-users and the general public. Studies show that the public perception of risk is closely tied to the available information, which may be negatively affected by...
Industrial biotechnology

...a future sustainable bio economy. In Industrial biotechnology enzymes and microorganisms are used to create products in the fields of fine- and bulk chemicals, pharmaceutical, food and feed, paper, textiles, energy, materials and polymers....
Lunar Plant - Hydroponic Plant Cultivation on a Lunar Base Using Nutrient Sources from Human Waste
...term in space, providing them with food, oxygen, and pure water. SINTEF will work together with the pioneer and world-leading group on closed biological systems, optimizing the plant cultivation compartment with recycling of nutrient elements and water, and reuse of nutrients from human waste. ...

...design, develop and test new oxide-based all solid-state batteries (ASSB) with long lifetime and low degradation during operation. Development of ASSB is important since these are fireproof and environmentally friendly batteries. Sustainable Energy - Batteries - Energy systems - Materials and Nanotech ...